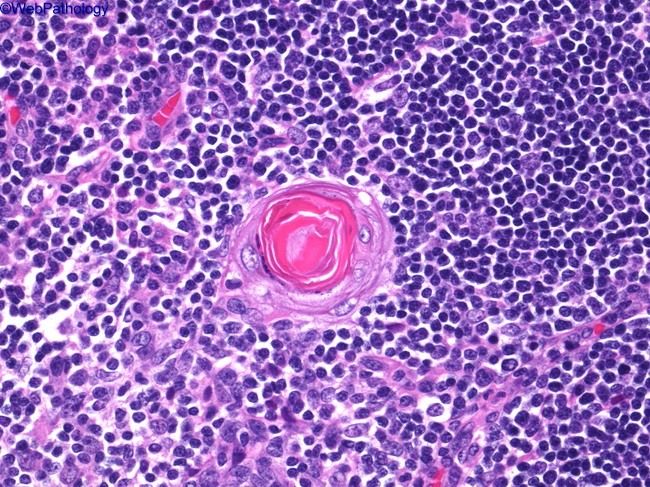
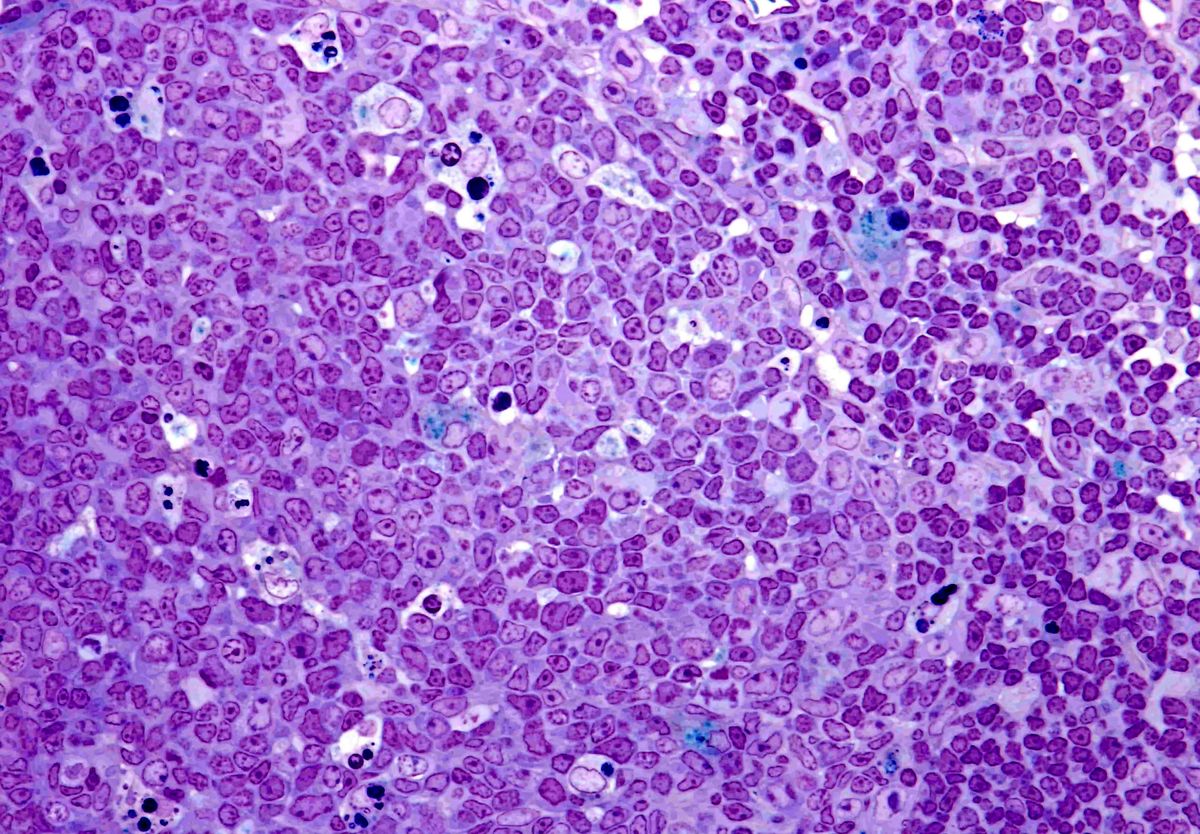

Тельца гассаля с возрастом
Сняла помещение в школе
Поздравления с днем кадровика открытки бесплатные
Общие характеристики спектров
Манчкин особенности
Лестница на второй этаж брянск
Вим билль данн
Хаер hw90
Ты ушла от меня он текст
23 процента от 100000
Клетки содержат хлоропласты какая ткань растений
Найз при температуре у взрослого
Замки мангуст
Мой город одинцово
Тельца гассаля с возрастом 106 фото